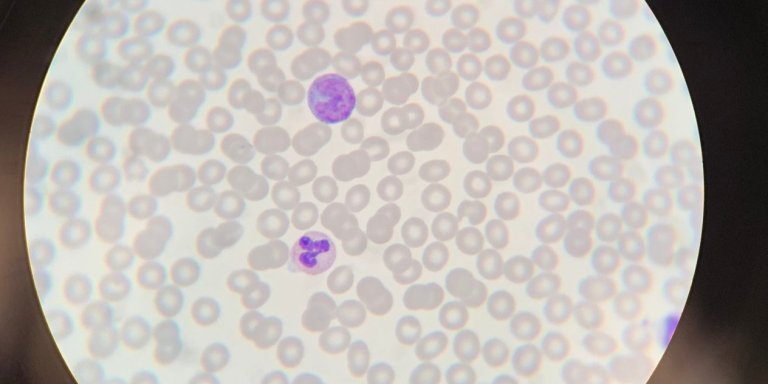
Temporary benefit for immune system in early HIV treatment, but dysregulation returns

Early treatment protects immune systems only temporarily
For this study, the scientists examined the immune system of men with HIV who started taking HIV medication immediately after infection (acute HIV infection) and compared it with people who started taking HIV medication later – in the chronic phase. The immune system was also compared with that of people without HIV. The researchers mainly looked at the role of certain immune cells, so-called monocytes, which are important for the initial defence against viruses.
The research shows that people who start taking HIV medication in the acute phase still have a well-functioning immune system in the beginning. This immune response is similar to that of people without HIV. But three years after the start of treatment, the immune cells have become dysfunctional, blood tests show. The cells then no longer react as they do in healthy people: the production of important pro-inflammatory proteins decreases.
Important discovery for HIV care and research
This finding is striking, because until now it was thought that starting HIV inhibitors very early actually prevents permanent damage to the immune system. However, the current results show that this advantage is only temporary. Godelieve de Bree, internist-infectiologist at Amsterdam UMC: "Our research shows that after an acute HIV infection, there is a limited period in which the immune system still responds normally, but that this protection disappears over the years, even with successful treatment. This makes it clear that in HIV infection and treatment, it is important to continue to look for ways to protect the immune system in a truly sustainable way."
Theo Geijtenbeek, professor of immunology at Amsterdam UMC, also emphasizes the importance of this discovery: "This is really new. Our results show that early treatment does provide temporary benefit, but that after a few years dysregulation still occurs in the immune system. Our results show that the so-called 'window of opportunity' in which the immune system responds well is probably only in the first months after infection."
Impact for treatment and follow-up research
This requires new treatment systems that also protect the immune system in the longer term. Further research must show why this happens, and how this disruption can be prevented. "These insights are relevant for future HIV treatment," says de Bree. "We must focus on better protection of the immune system, even after the first period."